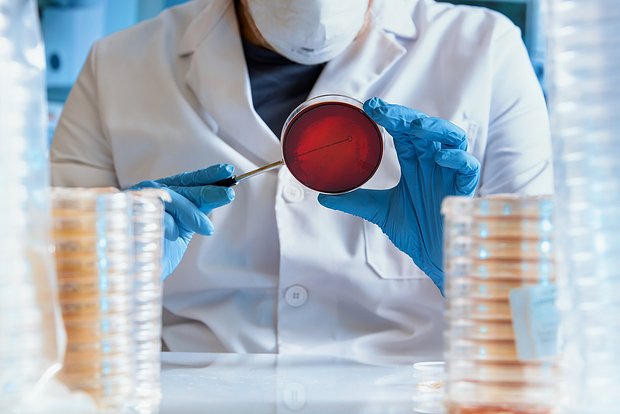

Специалисты по безопасности рассказали об уязвимостях, которые затрагивают миллиарды Android-смартфонов. Об этом сообщает издание Gadgets 360.
На проблему обратили внимание эксперты индийского агентства по кибербезопасности CERT-In (Indian Computer Emergency Response Team). Уязвимости нашли в десятках компонентов экосистемы Android. «Уязвимости вызваны недостатками в Framework, Android Runtime, System, Widevine DRM, Project Mainline, Kernel, Arm Components, Imagination Technologies, деталей MediaTek и Qualcomm», — заявили авторы отчета.
В компании отметили, что уязвимости можно применять в операционных системах (ОС) Android 13, 14, 15 и 16. С этим и связано такое огромное число подверженных взлому гаджетов. По их словам, успешная эксплуатация системных брешей позволяет злоумышленникам получать повышенные привилегии и извлекать из устройств конфиденциальную информацию.
В CERT-In заявили, что передали всю информацию в Google. В корпорации отреагировали на сообщение и выпустили патчи, исправляющие уязвимости. В заключение журналисты призвали пользователей обновить свои смартфоны.
Ранее исследователи Counterpoint Research рассказали, что корпорация Samsung выпала из топ-2 производителей складных смартфонов. По итогам второго квартала 2025 года лидером отрасли стала Huawei, Motorola разместилась на второй позиции, а Samsung оказалась лишь третьей.